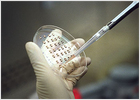
foto de la noticia

La Unión Europea cree que los países que se incorporarán el próximo 1 de mayo aún no están preparados. Los 10 aún tienen graves carencias que deben subsanar de forma inmediata si no quieren que la Unión Europea congele algunos capítulos a la hora de su ingreso en el club.
La Mesa del Parlamento vasco decidió ayer, con los votos de los representantes de PNV, EA e IU -los grupos que sostienen al Gobierno tripartito-, tramitar la propuesta de nuevo estatuto, conocida como plan Ibarretxe, por el procedimiento legislativo ordinario.
Turquía ha roto las negociaciones que celebraba con Estados Unidos para desplegar 10.000 soldados en Irak, ante la negativa del Consejo de Gobierno provisional de Irak y las diferencias sobre el lugar del despliegue.
Los 10 países candidatos que se incorporarán a la Unión Europea el 1 de mayo próximo sufren "importantes retrasos" en su preparación para entrar al club y, si no toman medidas "inmediatas", originarán "serias consecuencias que no deben ser subestimadas", según afirma la Comisión Europea.
Un mes después de que el Parlamento turco aprobara el envío de 10.000 soldados a Irak para apoyar a las fuerzas de ocupación encabezadas por Estados Unidos, el Gobierno de Ankara parece haber aparcado la operación militar en una vía muerta.
LA SITUACIÓN EN EL PAÍS VASCO
La Mesa del Parlamento vasco admitió ayer cursar el plan Ibarretxe por el procedimiento legislativo ordinario. Aunque la iniciativa del lehendakari se tramitará como cualquier otro proyecto de ley, la Mesa la calificó con la misma denominación con que la aprobó el Gobierno tripartito (PNV, EA e IU), Propuesta de Estatuto Político de la Comunidad de Euskadi.
Las viudas de tres capitanes asesinados por ETA en la plaza de la Cruz Verde de Madrid en febrero de 1992 increparon ayer al tribunal de la Audiencia Nacional, que decidió suspender el juicio contra los etarras Ignacio Etxebarria, Mortadelo, Gonzalo Rodríguez Cordero y José Gabriel Zabala Erasun.
El empuje del consumo y de la construcción están sosteniendo el crecimiento económico en España. El producto interior bruto (PIB) avanzó un 2,3% en el tercer trimestre del año, igual que en los tres meses anteriores, según el Banco de España, principalmente por la subida de una décima en el gasto de los hogares.
La decisión del Gobierno de Aznar de retirar a una parte del personal de la Embajada de España en Bagdad, aunque sea "temporal y parcial" y para efectuar "consultas", tiene todos los visos de un...
El derecho de crítica a la política de un Gobierno, propio o extranjero, es un pilar de las sociedades democráticas. Ese derecho es el que han ejercido los europeos sondeados en el Eurobarómetro...
Nadie esperaba que de la reunión Schröder-Aznar saliera un compromiso hispano-alemán sobre sus reconocidas divergencias a propósito del reparto de poder en la Unión Europea. Ambos dirigentes han...
La coalición formada por la derecha y los verdes quedó ayer de nuevo en minoría en el Parlamento Europeo en el sensible asunto de la financiación con dinero europeo de los ensayos con células madre procedentes de embriones.
Más de un centenar de escritores españoles, latinoamericanos y marroquíes se reúnen desde hoy en Sevilla para reflexionar sobre "los retos del escritor del siglo XXI". Éste es el título con el que se presenta el VII Congreso de Escritores de España, que resultará "bastante político, pero siempre independiente", según Andrés Sorel, secretario general de la Asociación Colegial de Escritores de España (ACE) y coordinador del encuentro.
El Grupo Gucci, una de las grandes cabeceras mundiales de la moda, se enfrenta a una situación crítica. A sus malos resultados económicos de este año se unió ayer una noticia que conmocionó al sector: Tom Ford, el diseñador tejano que en 1994 salvó Gucci de la ruina, anunció su marcha de la firma en abril de 2004.
Las siluetas de los indios nambikwara se recortan en el horizonte durante una de las competiciones de los Juegos Nacionales Indígenas que se celebran estos días en Palmas, en el norte de Brasil.
Ésta es la historia de una bala que atravesó el Atlántico. El entrenador del equipo Caja Segovia de fútbol sala, Carlos Alberto de Siqueira Lima Aranha, conocido como Beto, brasileño de 44 años, no oculta su felicidad a la vez que reconoce que ha vuelto a nacer, después de que unos atracadores le dispararan, hiriéndole en la cabeza, cuando acudía a una reunión familiar en casa de sus padres, en el populoso barrio Isla del Gobernador, de Río de Janeiro, la noche del viernes pasado.
La princesa Magdalena de Suecia y su hermano, el príncipe Carlos Felipe, no tienen que preocuparse por abonar la nota de sus visitas a los bares más "distinguidos" de Estocolmo. La casa invita, según afirma el diario Aftonbladet, el de mayor circulación del país, en su edición de ayer, después de haber investigado el asunto.
FÚTBOL
| Liga de Campeones
SANTIAGO SEGUROLA | Belgrado
Beckham acaudilló al Madrid en un empate, lo que no parece mucho cuando se tiene al Partizán como rival. Pero la noche fue cruda y emotiva, noche para futbolistas con coraje, porque no se regaló nada, ni se evitaron las patadas. A su manera, fue un excelente partido de Copa de Europa, con el necesario protagonismo de Casillas, magistral en lo suyo, que es salvar lo insalvable: los remates por fusilamiento.
PABLO CAMPOS | Vigo
La mejor versión del equipo de Balaídos se impone a un Ajax perseverante
LUIS MIGUEL HINOJAL
Di Vaio, que marcó dos goles a la Real Sociedad en Turín, llega a Anoeta en su mejor momento
Tele 5 reclamó ayer ante la Comisión de Control Parlamentario lo que considera un nuevo abuso de TVE. En una carta enviada a los diputados hace referencia al uso exclusivo por parte de la cadena pública de las primeras imágenes de la comparecencia ante los medios del príncipe Felipe junto a Letizia Ortiz.
ENRIC GONZÁLEZ | Roma
El Enzo, el automóvil más selecto de Ferrari, monta un motor de seis litros y 12 cilindros con una potencia de 650 caballos. Acelera de 0 a 100 en 3,7 segundos y alcanza una velocidad superior a los 300 kilómetros por hora. Cada uno de los 349 modelos fabricados se vendió por encargo a más de cien millones de las viejas pesetas, y ahora, en la reventa, cuesta mucho más.